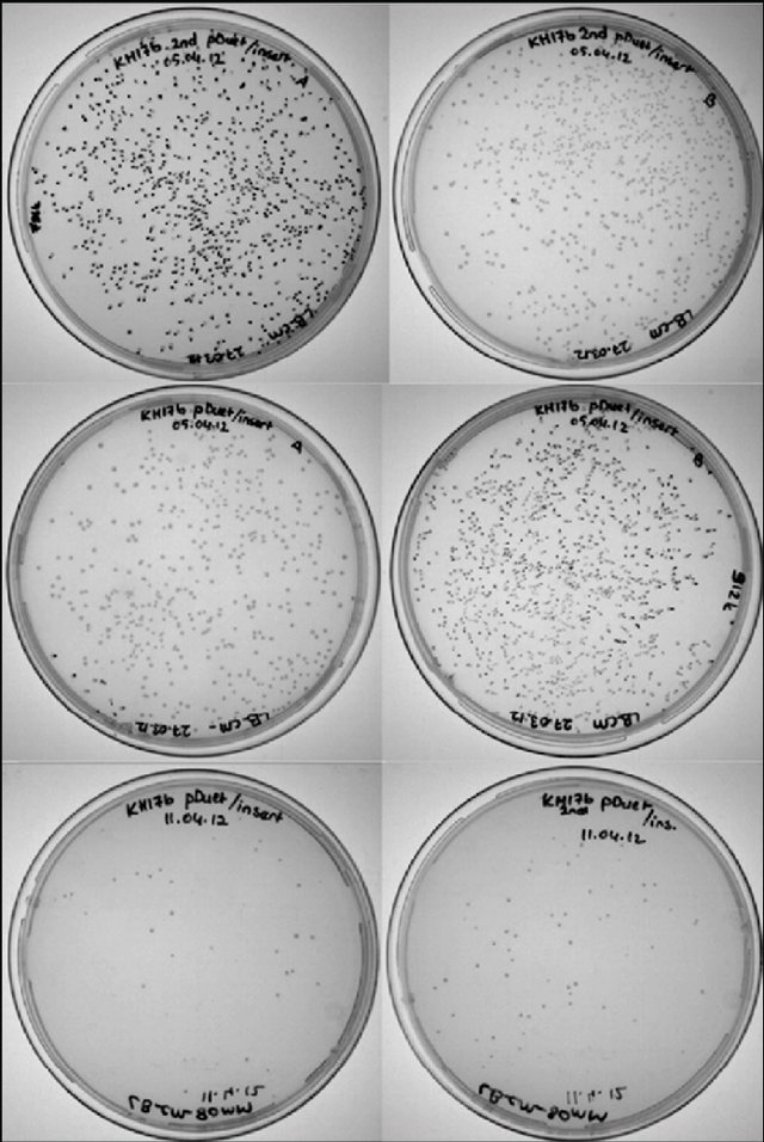
经过培养,在抗性平板上筛选克隆子,建立原始种子库

平板克隆

平板克隆形成实验 - 知乎
图片尺寸570x398
a549细胞平板克隆形成实验 结果和mtt不一致,改怎么强行解释呢,克隆
图片尺寸3265x2449
求助平板克隆实验
图片尺寸3388x3024
(1) 平板克隆形成实验:适用于贴壁生长的细胞和正常培养的细胞.
图片尺寸604x386
平板克隆实验,图片怎么样
图片尺寸1290x1296
cyclovirobuxine d inhibits cell proliferation and
图片尺寸1913x1413
平板克隆形成
图片尺寸1280x960
15 细胞的平板克隆形成能力
图片尺寸1575x888
再取进展中山大学再发文促进胃癌进展的新机制
图片尺寸660x501
过年这些行为可能会泄露你的隐私##国际数据隐私日
图片尺寸640x992
换机克隆
图片尺寸767x767
经mtt实验和平板克隆实验发现,虫草素可以显著抑制hepg-2细胞的活力和
图片尺寸660x301
经过培养,在抗性平板上筛选克隆子,建立原始种子库
图片尺寸764x1142
asus transformer pad tf303cl – review
图片尺寸1210x807
结合目前的消息,荣耀平板magicpad主打护眼超大屏和3d空间音频,这样的
图片尺寸2011x1280
上一期讲到了得到同源重组产物后进行转化,当平板长出单克隆,送测序
图片尺寸929x1189
整机平板99新ipadair2128g
图片尺寸852x1136
得不到阳性克隆可能是忽视了这些细节
图片尺寸629x449
ai资产管理平台fundguard融资1亿美金谷歌推出多模态视
图片尺寸554x241
molecular cancer| 重庆医科大学陈俊霞团队揭示circact
图片尺寸600x789